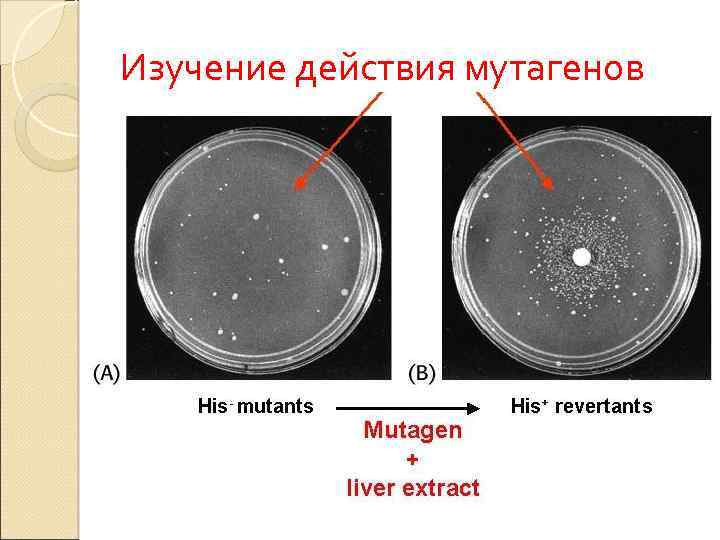
Изучение действия мутагенов

variability.ppt
- Количество слайдов: 48
 ИЗМЕНЧИВОСТЬ И ЕЕ ФОРМЫ Доцент А. В. Шапкина Тезисы с иллюстрациями
ИЗМЕНЧИВОСТЬ И ЕЕ ФОРМЫ Доцент А. В. Шапкина Тезисы с иллюстрациями
 Понятие об изменчивости Изменчивость –свойство организмов изменять признаки, полученные от родителей, или приобретать новые в процессе индивидуального развития Классификация изменчивости: - Онтогенетическая (возрастная) - Модификационная (фенотипическая) - Генотипическая (комбинативная и мутационная)
Понятие об изменчивости Изменчивость –свойство организмов изменять признаки, полученные от родителей, или приобретать новые в процессе индивидуального развития Классификация изменчивости: - Онтогенетическая (возрастная) - Модификационная (фенотипическая) - Генотипическая (комбинативная и мутационная)
 Онтогенетическая изменчивость проявляется в виде постоянного изменения признаков в процессе развития особи, реализации генотипа в фенотип при определенных условиях среды. ОНТОГЕНЕЗ Генотип Фенотип среда
Онтогенетическая изменчивость проявляется в виде постоянного изменения признаков в процессе развития особи, реализации генотипа в фенотип при определенных условиях среды. ОНТОГЕНЕЗ Генотип Фенотип среда
 Онтогенетическая изменчивость определяется: Дифференциальной активностью генома Механизмом включения и выключения генов Регуляцией экспрессии генов
Онтогенетическая изменчивость определяется: Дифференциальной активностью генома Механизмом включения и выключения генов Регуляцией экспрессии генов
 Онтогенетическая изменчивость
Онтогенетическая изменчивость
 Проявление действия генов в фенотипе определяется: Свойствами гена Особенностями проявления в признак Взаимодействием с другими генами
Проявление действия генов в фенотипе определяется: Свойствами гена Особенностями проявления в признак Взаимодействием с другими генами
 Свойства гена отражают свойства генетического материала и проявляются на всех уровнях его организации: генном, хромосомном, геномном. Свойства: самовоспроизведение, стабильность, изменение (мутирование), дискретность, специфичность, плейотропность, поле действия гена, время работы гена Гены обладают различной пенетрантностью и экспрессивностью.
Свойства гена отражают свойства генетического материала и проявляются на всех уровнях его организации: генном, хромосомном, геномном. Свойства: самовоспроизведение, стабильность, изменение (мутирование), дискретность, специфичность, плейотропность, поле действия гена, время работы гена Гены обладают различной пенетрантностью и экспрессивностью.
 ПЛЕЙОТРОПНОЕ ДЕЙСТВИЕ ГЕНА веснушки светлый цвет волос
ПЛЕЙОТРОПНОЕ ДЕЙСТВИЕ ГЕНА веснушки светлый цвет волос
 Взаимодействие генов Аллельные гены взаимодействуют по типу: Полного доминирования Неполного доминирования Кодоминирования Сверхдоминирования
Взаимодействие генов Аллельные гены взаимодействуют по типу: Полного доминирования Неполного доминирования Кодоминирования Сверхдоминирования
 Примеры взаимодействия аллельных генов ПОЛНОЕ ДОМИНИРОВАНИЕ КОДОМИНИРОВАНИЕ НЕПОЛНОЕ ДОМИНИРОВАНИЕ
Примеры взаимодействия аллельных генов ПОЛНОЕ ДОМИНИРОВАНИЕ КОДОМИНИРОВАНИЕ НЕПОЛНОЕ ДОМИНИРОВАНИЕ
 Взаимодействие генов Неаллельные гены взаимодействуют по типу : Комплементарности Эпистаза Полимерии
Взаимодействие генов Неаллельные гены взаимодействуют по типу : Комплементарности Эпистаза Полимерии
 Комплементарность наследование форм гребня у петухов А – гороховидный Б – розовидный В –листовидный Г - ореховидный ПОЛИМЕРИЯ
Комплементарность наследование форм гребня у петухов А – гороховидный Б – розовидный В –листовидный Г - ореховидный ПОЛИМЕРИЯ
 Модификационная изменчивость связана с модификациями. Модификации – фенотипические различия между особями одного вида при воздействии среды Изменения могут быть полезными (адаптивными), вредными или нейтральными Предел модификаций определяется нормой реакции организма
Модификационная изменчивость связана с модификациями. Модификации – фенотипические различия между особями одного вида при воздействии среды Изменения могут быть полезными (адаптивными), вредными или нейтральными Предел модификаций определяется нормой реакции организма
 Модификации: Не наследуются Возникают на разных этапах онтогенеза Кратковременны Однонаправленны Адекватны воздействию среды Приспособительны Модификации способствуют адаптации организма к условиям окружающей среды, сохраняют гомеостаз организма
Модификации: Не наследуются Возникают на разных этапах онтогенеза Кратковременны Однонаправленны Адекватны воздействию среды Приспособительны Модификации способствуют адаптации организма к условиям окружающей среды, сохраняют гомеостаз организма
 Норма реакции Пределы модификаций определяются нормой реакции (варьирование признака соответственно своего генотипа) Норма реакции наследуется, она складывалась исторически в процессе филогенеза. Норма реакции по отношению к признакам может быть: узкой, широкой, однозначной. широкая однозначная
Норма реакции Пределы модификаций определяются нормой реакции (варьирование признака соответственно своего генотипа) Норма реакции наследуется, она складывалась исторически в процессе филогенеза. Норма реакции по отношению к признакам может быть: узкой, широкой, однозначной. широкая однозначная
 Модификационная изменчивость изучается методами: Близнецовый метод (соотносительная роль наследственности и среды и развитии признака) Метод вариационной статистики (изучение количественных признаков)
Модификационная изменчивость изучается методами: Близнецовый метод (соотносительная роль наследственности и среды и развитии признака) Метод вариационной статистики (изучение количественных признаков)
 Комбинативная изменчивость Уникальность генотипа обусловлена комбинативной изменчивостью
Комбинативная изменчивость Уникальность генотипа обусловлена комбинативной изменчивостью
 Оплодотворение
Оплодотворение
 Комбинативная изменчивость Результат: новые сочетания аллелей в генотипе Процессы: гаметогенез (мейоз) и оплодотворение Цитогенетические основы: кроссинговер, случайное независимое расхождение хромосом в анафазу I и хроматид в анафазу II
Комбинативная изменчивость Результат: новые сочетания аллелей в генотипе Процессы: гаметогенез (мейоз) и оплодотворение Цитогенетические основы: кроссинговер, случайное независимое расхождение хромосом в анафазу I и хроматид в анафазу II

 Мутационная изменчивость Мутации - качественные, внезапные, устойчивые изменения в генотипе. Классификация мутаций: по уровню организации наследственного материала: генные, хромосомные, геномные по происхождению: спонтанные, индуцированные
Мутационная изменчивость Мутации - качественные, внезапные, устойчивые изменения в генотипе. Классификация мутаций: по уровню организации наследственного материала: генные, хромосомные, геномные по происхождению: спонтанные, индуцированные
 Генные мутации вызваны изменением последовательности нуклеотидов. Причины: изменение количества нуклеотидов (выпадение или вставка), замена нуклеотидов по типу транзиций и трансверсий Результат: изменение состава нуклеотидов в кодоне и изменение функции (миссенс и нонсенс – мутации) Генные мутации приводят к появлению новых аллелей, новых генотипов и новых фенотипов, что обеспечивает фенотипическое разнообразие организмов и определяет гетерогенность и полиморфизм популяций Генные мутации вызывают генные (молекулярные) болезни.
Генные мутации вызваны изменением последовательности нуклеотидов. Причины: изменение количества нуклеотидов (выпадение или вставка), замена нуклеотидов по типу транзиций и трансверсий Результат: изменение состава нуклеотидов в кодоне и изменение функции (миссенс и нонсенс – мутации) Генные мутации приводят к появлению новых аллелей, новых генотипов и новых фенотипов, что обеспечивает фенотипическое разнообразие организмов и определяет гетерогенность и полиморфизм популяций Генные мутации вызывают генные (молекулярные) болезни.
 Генные мутации
Генные мутации
 Изменение молекулы ДНК
Изменение молекулы ДНК
 Серповидноклеточная анемия
Серповидноклеточная анемия
 Типы репарации Световая Темновая
Типы репарации Световая Темновая
 Мутации у мышей у дрозофил
Мутации у мышей у дрозофил
 Генные болезни нейрофиброматоз полидактилия пигментная ксеродерма
Генные болезни нейрофиброматоз полидактилия пигментная ксеродерма
 Хромосома
Хромосома
 Хромосомные мутации Изменение структуры хромосом
Хромосомные мутации Изменение структуры хромосом
 Хромосомные аберрации
Хромосомные аберрации
 Геномные мутации Изменение числа отдельных хромосом - гетероплоидия или нарушение геномного числа хромосом Механизм геномных мутаций
Геномные мутации Изменение числа отдельных хромосом - гетероплоидия или нарушение геномного числа хромосом Механизм геномных мутаций
 Роль мутаций в возникновении заболеваний Хромосомные и геномные мутации являются причиной хромосомных болезней синдром Дауна заячья губа
Роль мутаций в возникновении заболеваний Хромосомные и геномные мутации являются причиной хромосомных болезней синдром Дауна заячья губа
 Мутагенез спонтанный Спонтанный мутагенез -возникновение мутаций под влиянием естественных факторов среды Гипотезы возникновения: нарушение процесса репликации и репарации ДНК, естественная радиация, наличие геновмутаторов и др.
Мутагенез спонтанный Спонтанный мутагенез -возникновение мутаций под влиянием естественных факторов среды Гипотезы возникновения: нарушение процесса репликации и репарации ДНК, естественная радиация, наличие геновмутаторов и др.
 Особенности спонтанного мутагенеза Определенная частота мутаций Непрерывность Ненаправленность Биологическая характеристика вида Частота появления мутаций подвергается генному контролю (три «р» - репарация, репликация, рекомбинация) и естественному отбору
Особенности спонтанного мутагенеза Определенная частота мутаций Непрерывность Ненаправленность Биологическая характеристика вида Частота появления мутаций подвергается генному контролю (три «р» - репарация, репликация, рекомбинация) и естественному отбору
 Индуцированный мутагенез Мутации возникают под влиянием направленых факторов среды мутагенов. Мутагены : Физические Химические Биологические
Индуцированный мутагенез Мутации возникают под влиянием направленых факторов среды мутагенов. Мутагены : Физические Химические Биологические

 Мутагены-факторы внешней среды
Мутагены-факторы внешней среды
 Физические мутагены электромагнитное излучение радиоактивное излучение
Физические мутагены электромагнитное излучение радиоактивное излучение
 Химические мутагены
Химические мутагены
 Биологические мутагены
Биологические мутагены
 Эффект мутагенов ВЛИЯНИЕ АЛКОГОЛЯ
Эффект мутагенов ВЛИЯНИЕ АЛКОГОЛЯ
 Мутагенез и канцерогенез
Мутагенез и канцерогенез
 Тест системы 1. Исследование генных мутаций у микроорганизмов 2. Выявление доминантных летальных мутаций у мышей 3. Цитологический анализ изменения хромосом (хромосомные и геномные мутации) в лимфоцитах человека и костном мозге млекопитающих
Тест системы 1. Исследование генных мутаций у микроорганизмов 2. Выявление доминантных летальных мутаций у мышей 3. Цитологический анализ изменения хромосом (хромосомные и геномные мутации) в лимфоцитах человека и костном мозге млекопитающих
 Используемые тест-системы 1. 2. 3.
Используемые тест-системы 1. 2. 3.
Изучение действия мутагенов
Изучение действия мутагенов
 Антимутагены
Антимутагены
 Защитим нашу планету от мутагенов!
Защитим нашу планету от мутагенов!


